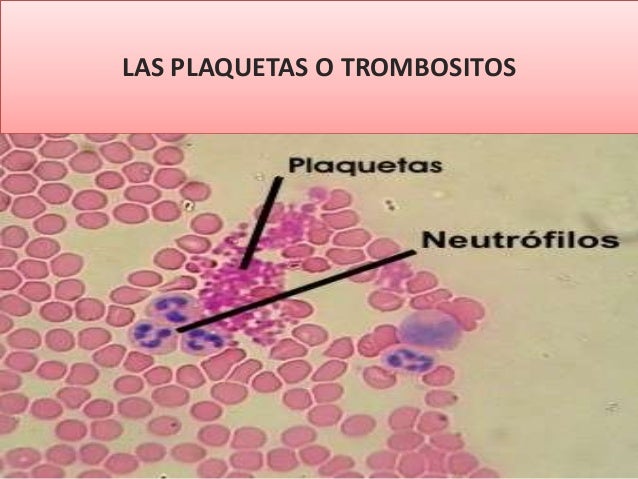

Tamaño: 2 a
3µm
Forma: indefinida
Relación núcleo citoplasma: no aplica
Descripción del núcleo/citoplasma: célula anucleada, citoplasma en
el cual se diferencia una fase sol, donde se hallan los principales gránulos,
denominados gránulos densos, y en donde se almacenan fundamentalmente las
sustancias proagregantes como el ADP.
(Tortora, 2007)
URL DE LA IMAGEN: http://es.slideshare.net/valeriarosasluna/las-plaquetas-o-trombositos
REFERENCIA BIBLIOGRAFICA:
Tortora, A. (2007).
Introducción a la Inmunología. (9na Ed.). España: Panamericana.
No hay comentarios:
Publicar un comentario